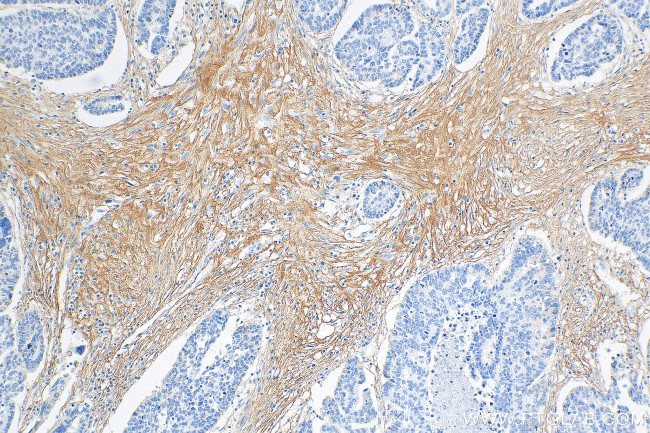
COL3A1 Antibody in Immunohistochemistry (Paraffin) (IHC (P))

Search
Proteintech
COL3A1 Monoclonal Antibody (3B1F3)
{{$productOrderCtrl.translations['antibody.pdp.commerceCard.promotion.promotions']}}
{{$productOrderCtrl.translations['antibody.pdp.commerceCard.promotion.viewpromo']}}
{{$productOrderCtrl.translations['antibody.pdp.commerceCard.promotion.promocode']}}: {{promo.promoCode}} {{promo.promoTitle}} {{promo.promoDescription}}. {{$productOrderCtrl.translations['antibody.pdp.commerceCard.promotion.learnmore']}}
产品信息
68320-1-IG
种属反应
宿主/亚型
分类
类型
克隆号
抗原
偶联物
形式
纯化类型
保存液
内含物
保存条件
运输条件
产品详细信息
Immunogen sequence: DGTSGHPGPI GPPGPRGNRG ERGSEGSPGH PGQPGPPGPP GAPGPCCGGV GAAAIAGIGG EKAGGFAPYY GDEPMDFKIN TDEIMTSLKS VNGQIESLIS PDGSRKNPAR NCRDLKFCHP ELKSGEYWVD PNQGCKLDAI KVFCNMETGE TCISANPLNV PRKHWWTDSS AEKKHVWFGE SMDGGFQFSY GNPELPEDVL DVQLAFLRLL SSRASQNITY HCKNSIAYMD QASGNVKKAL KLMGSNEGEF KAEGNSKFTY TVLEDGCTKH TGEWSKTVFE YRTRKAVRLP IVDIAPYDIG GPDQEFGVDV GPVCFL
靶标信息
Collagen III is a fibrillar collagen that is found in extensible connective tissues such as skin, lung, and the vascular system, frequently in association with type I Collagen. Mutations in th gene are associated with Ehlers Danlos syndrome type IV, and with aortic and arterial aneurysms. Although alternate transcripts have been detected for this gene, they are the result of mutations; these mutations alter splicing, often leading to the exclusion of multiple exons.
仅用于科研。不用于诊断过程。未经明确授权不得转售。
篇参考文献 (0)
生物信息学
蛋白别名: alpha-1 type III collagen; alpha-1(III) procollagen; alpha1 (III) collagen; COL 3; COL3; COL3 alpha 1; Collagen 3; Collagen alpha-1(III) chain; collagen, fetal; collagen, type III, alpha 1; collagen, type III, alpha 1 (Ehlers-Danlos syndrome type IV, autosomal dominant); Collagen3; Ehlers-Danlos syndrome type IV, autosomal dominant; FLJ34534; MGC93704; minisatellite 10w detected by probe MMS10; pro alpha 1 type III collagen; procollagen, type III, alpha 1; type III collagen; unnamed protein product
基因别名: AW550625; Col3a-1; COL3A1; EDS4A; EDSVASC; mKIAA4231; MMS10-W; Ms10w; PMGEDSV
UniProt ID: (Human) P02461, (Mouse) P08121, (Rat) P13941
Entrez Gene ID: (Human) 1281, (Pig) 100152001, (Rabbit) 100009177, (Mouse) 12825, (Rat) 84032